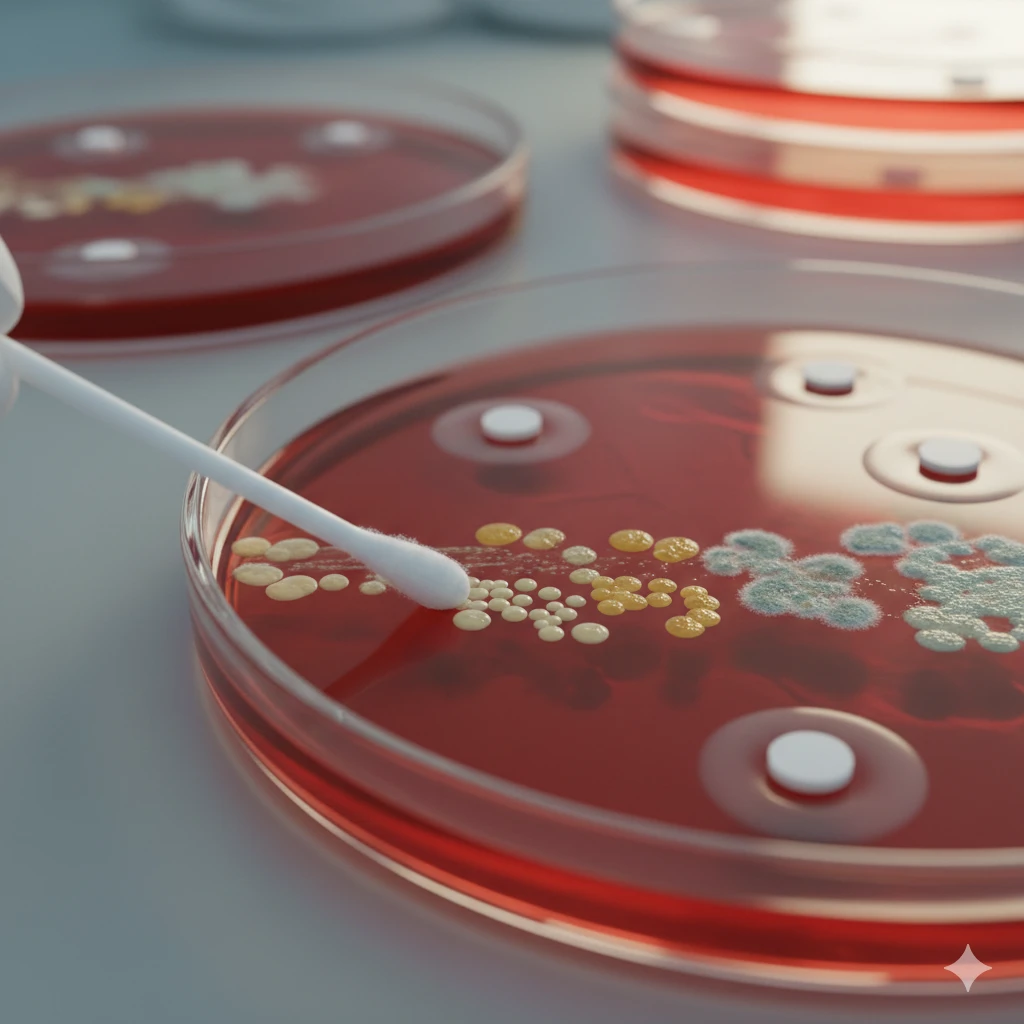
Swab Culture And Sensitivity

تفاصيل التحليل
مزرعة وحساسية مسحة من الجرح (Swab Culture and Sensitivity)
اضمن التئام جروحك بشكل سليم وسريع. يكشف هذا الفحص عن نوع البكتيريا المسببة للالتهاب ويحدد العلاج الدقيق بالمضادات الحيوية لضمان التعافي التام ومنع المضاعفات.
الصورة التوضيحية المرتبطة بهذا التحليل